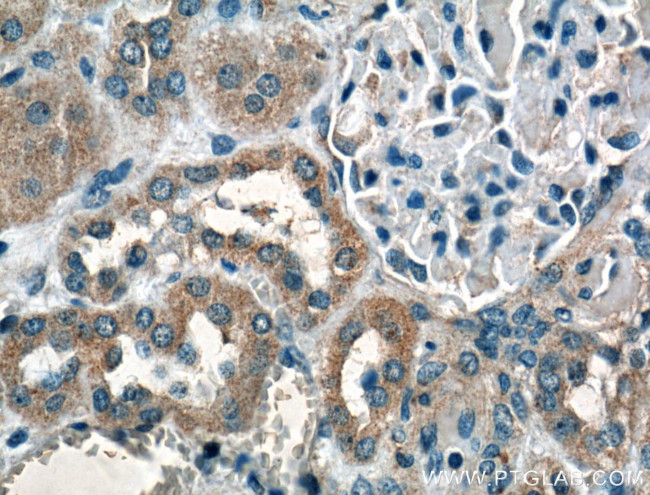
PFTK1 Antibody in Immunohistochemistry (Paraffin) (IHC (P))

Search
Proteintech
PFTK1 Polyclonal Antibody
{{$productOrderCtrl.translations['antibody.pdp.commerceCard.promotion.promotions']}}
{{$productOrderCtrl.translations['antibody.pdp.commerceCard.promotion.viewpromo']}}
{{$productOrderCtrl.translations['antibody.pdp.commerceCard.promotion.promocode']}}: {{promo.promoCode}} {{promo.promoTitle}} {{promo.promoDescription}}. {{$productOrderCtrl.translations['antibody.pdp.commerceCard.promotion.learnmore']}}
产品信息
21612-1-AP
种属反应
已发表种属
宿主/亚型
分类
类型
抗原
偶联物
形式
浓度
规格
纯化类型
保存液
内含物
保存条件
运输条件
产品详细信息
This antibody is specific to PFTK1.
Immunogen sequence: IFVEMIQGV AAFPGMKDIQ DQLERIFLVL GTPNEDTWPG VHSLPHFKPE RFTLYSSKNL RQAWNKLSYV NHAEDLASKL LQCSPKNRLS AQAALSHEYF SDLPPRLWEL TDMSSIFTVP NVRLQPEAGE SMRAFGKNNS YGKSLSNSKH (303-451 aa encoded by BC136477)
靶标信息
CDK14 (PFTK1)/cyclin Y is a member of the CDC2-related protein kinase family which is expressed primarily in the postnatal and adult nervous system. CDK14 is expressed at high levels in brain, pancreas, kidney, heart, testis, and ovary. CDK14 amino acid residue ser119 is required for its interaction with all four 14-3-3 isoforms, while ser120 may contribute slightly to CDK14 binding. CDK14 acts as a cyclin-dependent kinase that regulates cell cycle progression and cell proliferation. Overexpression of CDK14 predicts resistance to chemotherapy in patients with esophageal squamous cell carcinoma.
仅用于科研。不用于诊断过程。未经明确授权不得转售。
生物信息学
蛋白别名: Cell division protein kinase 14; Cyclin-dependent kinase 14; hPFTAIRE1; PFTAIRE protein kinase 1; Serine/threonine-protein kinase PFTAIRE-1; unnamed protein product
基因别名: CDK14; KIAA0834; mKIAA0834; PFTAIRE1; PFTK1
UniProt ID: (Human) O94921, (Mouse) O35495
Entrez Gene ID: (Human) 5218, (Rat) 362316, (Mouse) 18647